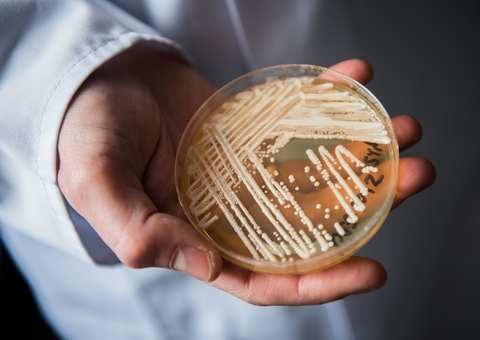
Três casos de superfungo Candidas auris é confirmada no Brasil

Balanço da Associação Brasileira da Indústria de Alimentos (ABIA) registrou queda de US$ 300 milhões na exportação de alimentos industrializados em agosto, equivalente a redução de 4,8% em com comparação a julho.
Segundo o levantamento, as exportações somaram US$ 5,9 bilhões em agosto. Deste volume, US$ 332,7 milhões para os Estados Unidos, o que representa uma queda de 27,7% em relação a julho e de 19,9% na comparação com agosto de 2024.
O resultado reflete o aumento das tarifas de 50% impostas pelos Estados Unidos aos produtos brasileiros, além da antecipação dos embarques em julho antes da entrada em vigor da taxação.
Em julho, os EUA haviam importado US$ 460,1 milhões em alimentos industrializados do Brasil.
Os produtos mais afetados para os EUA foram açúcares (recuo de 69,5% em agosto na comparação com julho), proteínas animais (- 45,8%) e preparações alimentícias (- 37,5%).
O desempenho das exportações nos dois últimos meses evidencia uma inflexão clara: o crescimento expressivo de julho foi seguido por ajuste em agosto, sobretudo nos EUA, impactados pela nova tarifa, enquanto a China reforçou seu papel como mercado âncora”, analisa João Dornellas, presidente executivo da ABIA, em nota. Para o representante, a queda observada em agosto mostra que o país precisa diversificar seus parceiros comerciais e aumentar sua capacidade de negociação.
A queda para o mercado norte-americano coincidiu com um aumento substancial das vendas para o México, que comprou um total de US$ 221,15 milhões (3,8% do total), principalmente de proteínas animais.
"O avanço do México, que coincide com a retração das vendas aos Estados Unidos, indica um possível redirecionamento de fluxos e a abertura de novas rotas comerciais, movimento que ainda requer monitoramento para identificar se terá caráter estrutural ou apenas conjuntural", explica a nota da associação.
No total, os mexicanos compraram 43% a mais de produtores brasileiros em agosto, sendo o mercado que mais aumentou a participação no período.
A perspectiva é que o impacto mais expressivo seja sentido no acumulado do ano. Segundo a ABIA, a estimativa é de que as vendas de alimentos atingidos pelo tarifaço para o mercado norte-americano acumulem, entre agosto e dezembro, queda de 80%, com perda acumulada de US$ 1,351 bilhão.
China
A China, maior comprador de alimentos industrializados, adquiriu US$ 1,32 bilhão em produtos, alta de 10,9% em relação a julho e de 51%, em relação a agosto de 2024. A fatia chinesa representa 22,4% do total exportado em agosto deste ano.
O mercado externo representa 28% do faturamento do setor.
Já os países da Liga Árabe reduziram em 5,2% as compras em agosto em relação a julho, que somaram US$ 838,4 milhões. A União Europeia importou US$ 657 milhões em alimentos, redução de 14,8% sobre julho e de 24,6% quando comparado com agosto de 2024.
De janeiro a julho de 2025, as exportações gerais totalizaram US$ 36,44 bilhões, representando uma queda de 0,3% no mesmo período de 2024, em razão da diminuição de produção do açúcar na entressafra.
Suco de laranja
Setor que não foi taxado, a indústria de suco de laranja teve crescimento de 6,8% em agosto em relação ao mesmo mês do ano passado, e queda de 11% frente a julho, em razão da antecipação de embarques.
Empregos no setor
A indústria de alimentos registrou, em julho, 2,114 milhões de postos de trabalho formais e diretos. No comparativo interanual, foram criados, de julho de 2024 a julho de 2025, 67,1 mil novas vagas, o que representou um crescimento de 3,3%.
Neste ano, foram 39,7 mil empregos diretos novos e outros 159 mil postos abertos na cadeia produtiva, em setores como agricultura, pecuária, embalagens, máquinas e equipamentos.
*Com informações da Agência Brasil

Aviso